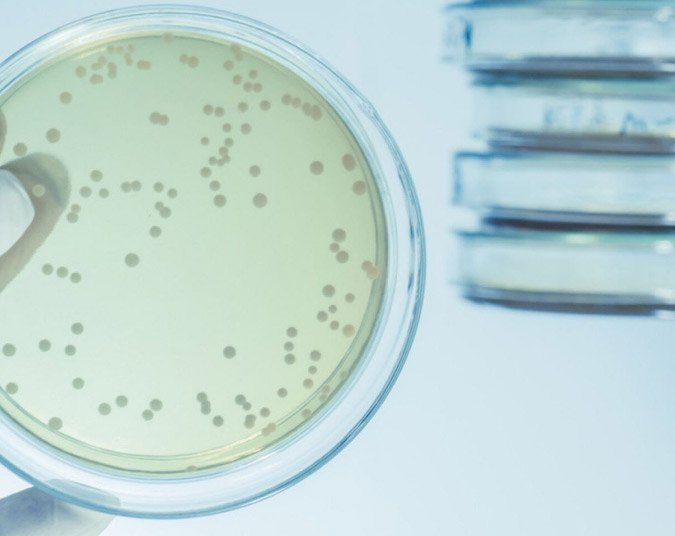

Geno engaged MOCA fragrances (experienced perfumers) to conduct a study of 105 common fragrance ingredients and 4 diluents to test compatibility and conduct organoleptic blotter evaluations. Each ingredient and diluent were evaluated at multiple dilutions, testing for solubility and comparable odor performance during wet and dry-down periods. This generated more than 1200 data points to derive conclusions.